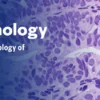

Breast Pathology – The Pathology of Neoplastic Diseases 2025 (Videos with subtitles + Slides)
Specialties
Specialties – Anatomic Pathology, Breast Medical Oncology, Breast Surgery, Gynecologic Oncology, Head and Neck Oncology, Head and Neck Surgery, Pathology
Overview
This on-demand module provides a current review of breast pathology, a focused subspecialty from the 2025 Pathology of Neoplastic Diseases course, originally held live from April 27–29, 2025. Topics include core biopsy interpretation, spindle cell lesions, papillary proliferations, and invasive lobular carcinoma. Sessions also address fibroepithelial neoplasms, biomarker testing, and small glandular proliferations, with insights into molecular diagnostics and AI applications. The breast pathology slide seminar is also included.
For a detailed overview of topics covered, please refer to the brochure from the live course and the Breast Pathology agenda from Sunday, April 27, moderated by Dr. Edi Brogi (page 6).
The target audience for this program includes practicing pathologists, both in academic and private practice environments, as well as residents and fellows in pathology who wish to broaden their understanding of neoplastic diseases.
Objectives
At the conclusion of this course, attendees will be able to:
- Label current classifications and diagnostic criteria for tumors and tumor-like lesions
- Highlight the appropriate use of ancillary diagnostic techniques
- Discuss differential diagnoses and understand the practical, problem- oriented approach
- Identify clinical pathological features of the various tumor entities